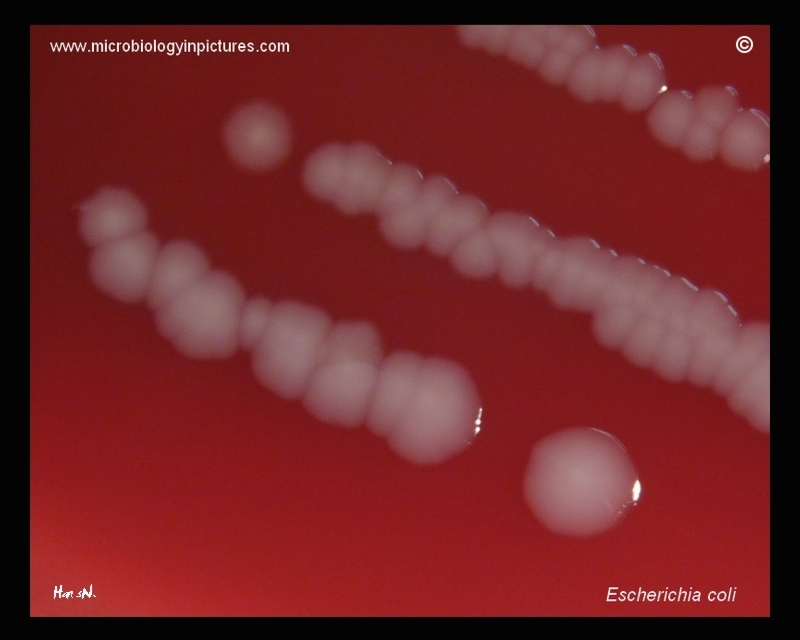

E.coli colonies on blood agar. Convex, circular colonies with smooth margin. Here without beta-hemolysis (gamma-hemolysis).
Cultivation 24 hours, 37°C in an aerobic atmosphere.
E.coli colonies on blood agar. Convex, circular colonies with smooth margin. Here without beta-hemolysis (gamma-hemolysis).
Cultivation 24 hours, 37°C in an aerobic atmosphere.